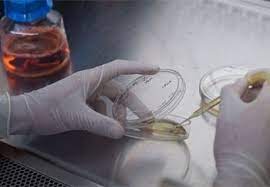
Ph.D. in Stem Cell Biology and Regenerative Medicine, Introduction, Admission Registration, Eligibility, Duration, Fees, Syllabus 2024

Graphic Era Hill University Admission Open
Graphic Era Hill University Highlights
| Institute Type | Private University |
| Name of the Institute | Graphic Era Hill University |
| Established | |
| Address | Graphic Era Hill University Bell Road, Clement Town Dehradun Uttarakhand |
| City | Dehradun-Uttarakhand |
| State | Uttarakhand |
| Pincode | 307026 |
| Landline | 1800 890 6027, 1800 270 1280 |
| admissions@gehu.ac.in or enquiry@gehu.ac.in | |
| Website | www.gehu.ac.in |
Are you intreseted this University
Suggested Communities
×
![]()
Blogs
Discover More university




.jpg)